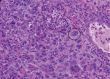

Cervical Tuberculosis Mimicking Tumor Persistence: A Case Report
- PMID: 39006988
- PMCID: PMC11239984
- DOI: 10.47895/amp.v58i11.8011
Cervical Tuberculosis Mimicking Tumor Persistence: A Case Report
Abstract
Tuberculosis can coexist with malignancy in the same organ, but cancer with TB in the cervix is rare. This is a case of cervical tuberculosis diagnosed in a cervical cancer patient after concurrent chemoradiotherapy and brachytherapy. This is the case of a 38-year-old G2P2 (2002) diagnosed with squamous cell carcinoma, large cell non-keratinizing cervix, Stage IIIB. The patient underwent concurrent chemoradiotherapy and brachytherapy. One month after the last brachytherapy dose, the attending physician noted a nodularity on the anterior lip of the cervix. A cervical punch biopsy was done to rule out tumor persistence. The histopathology revealed chronic granulomatous inflammation with Langhan's type multinucleated giant cells consistent with tuberculous infection. She was diagnosed with cervical tuberculosis, postulated to be from latent TB reactivation, and was given Anti-Koch's medication for six months. After receiving Anti-Koch's treatment, the cervical nodularity was no longer appreciated, and the rest of the cervix was smooth on palpation. Her Pap Test was negative for any intraepithelial lesion and was declared with no evidence of carcinoma. A possible latent TB infection should always be screened in cancer patients from high-burden areas or those with close contact treated for tuberculosis because immunosuppression during cancer treatment can cause the reactivation of tuberculous disease. Cervical tuberculosis complicating cervical malignancy is treatable with Anti-Koch's therapy and has not been shown to affect the course of the carcinoma.
Keywords: cervical carcinoma; cervical tuberculosis; genitourinary tuberculosis; latent tuberculosis.
© 2024 Acta Medica Philippina.
Conflict of interest statement
The authors declare that they have no known competing financial interests or personal relationships that could have appeared to influence the work reported in this paper.
Figures

References
-
- World Health Organization . Global Tuberculosis Report: Executive Summary 2020. World Heal Organ. 2020.
-
- Varma T. Tuberculosis of the female genital tract | GLOWM. Global Library of Women’s Medicine. 2008.
Publication types
LinkOut - more resources
Full Text Sources
Research Materials